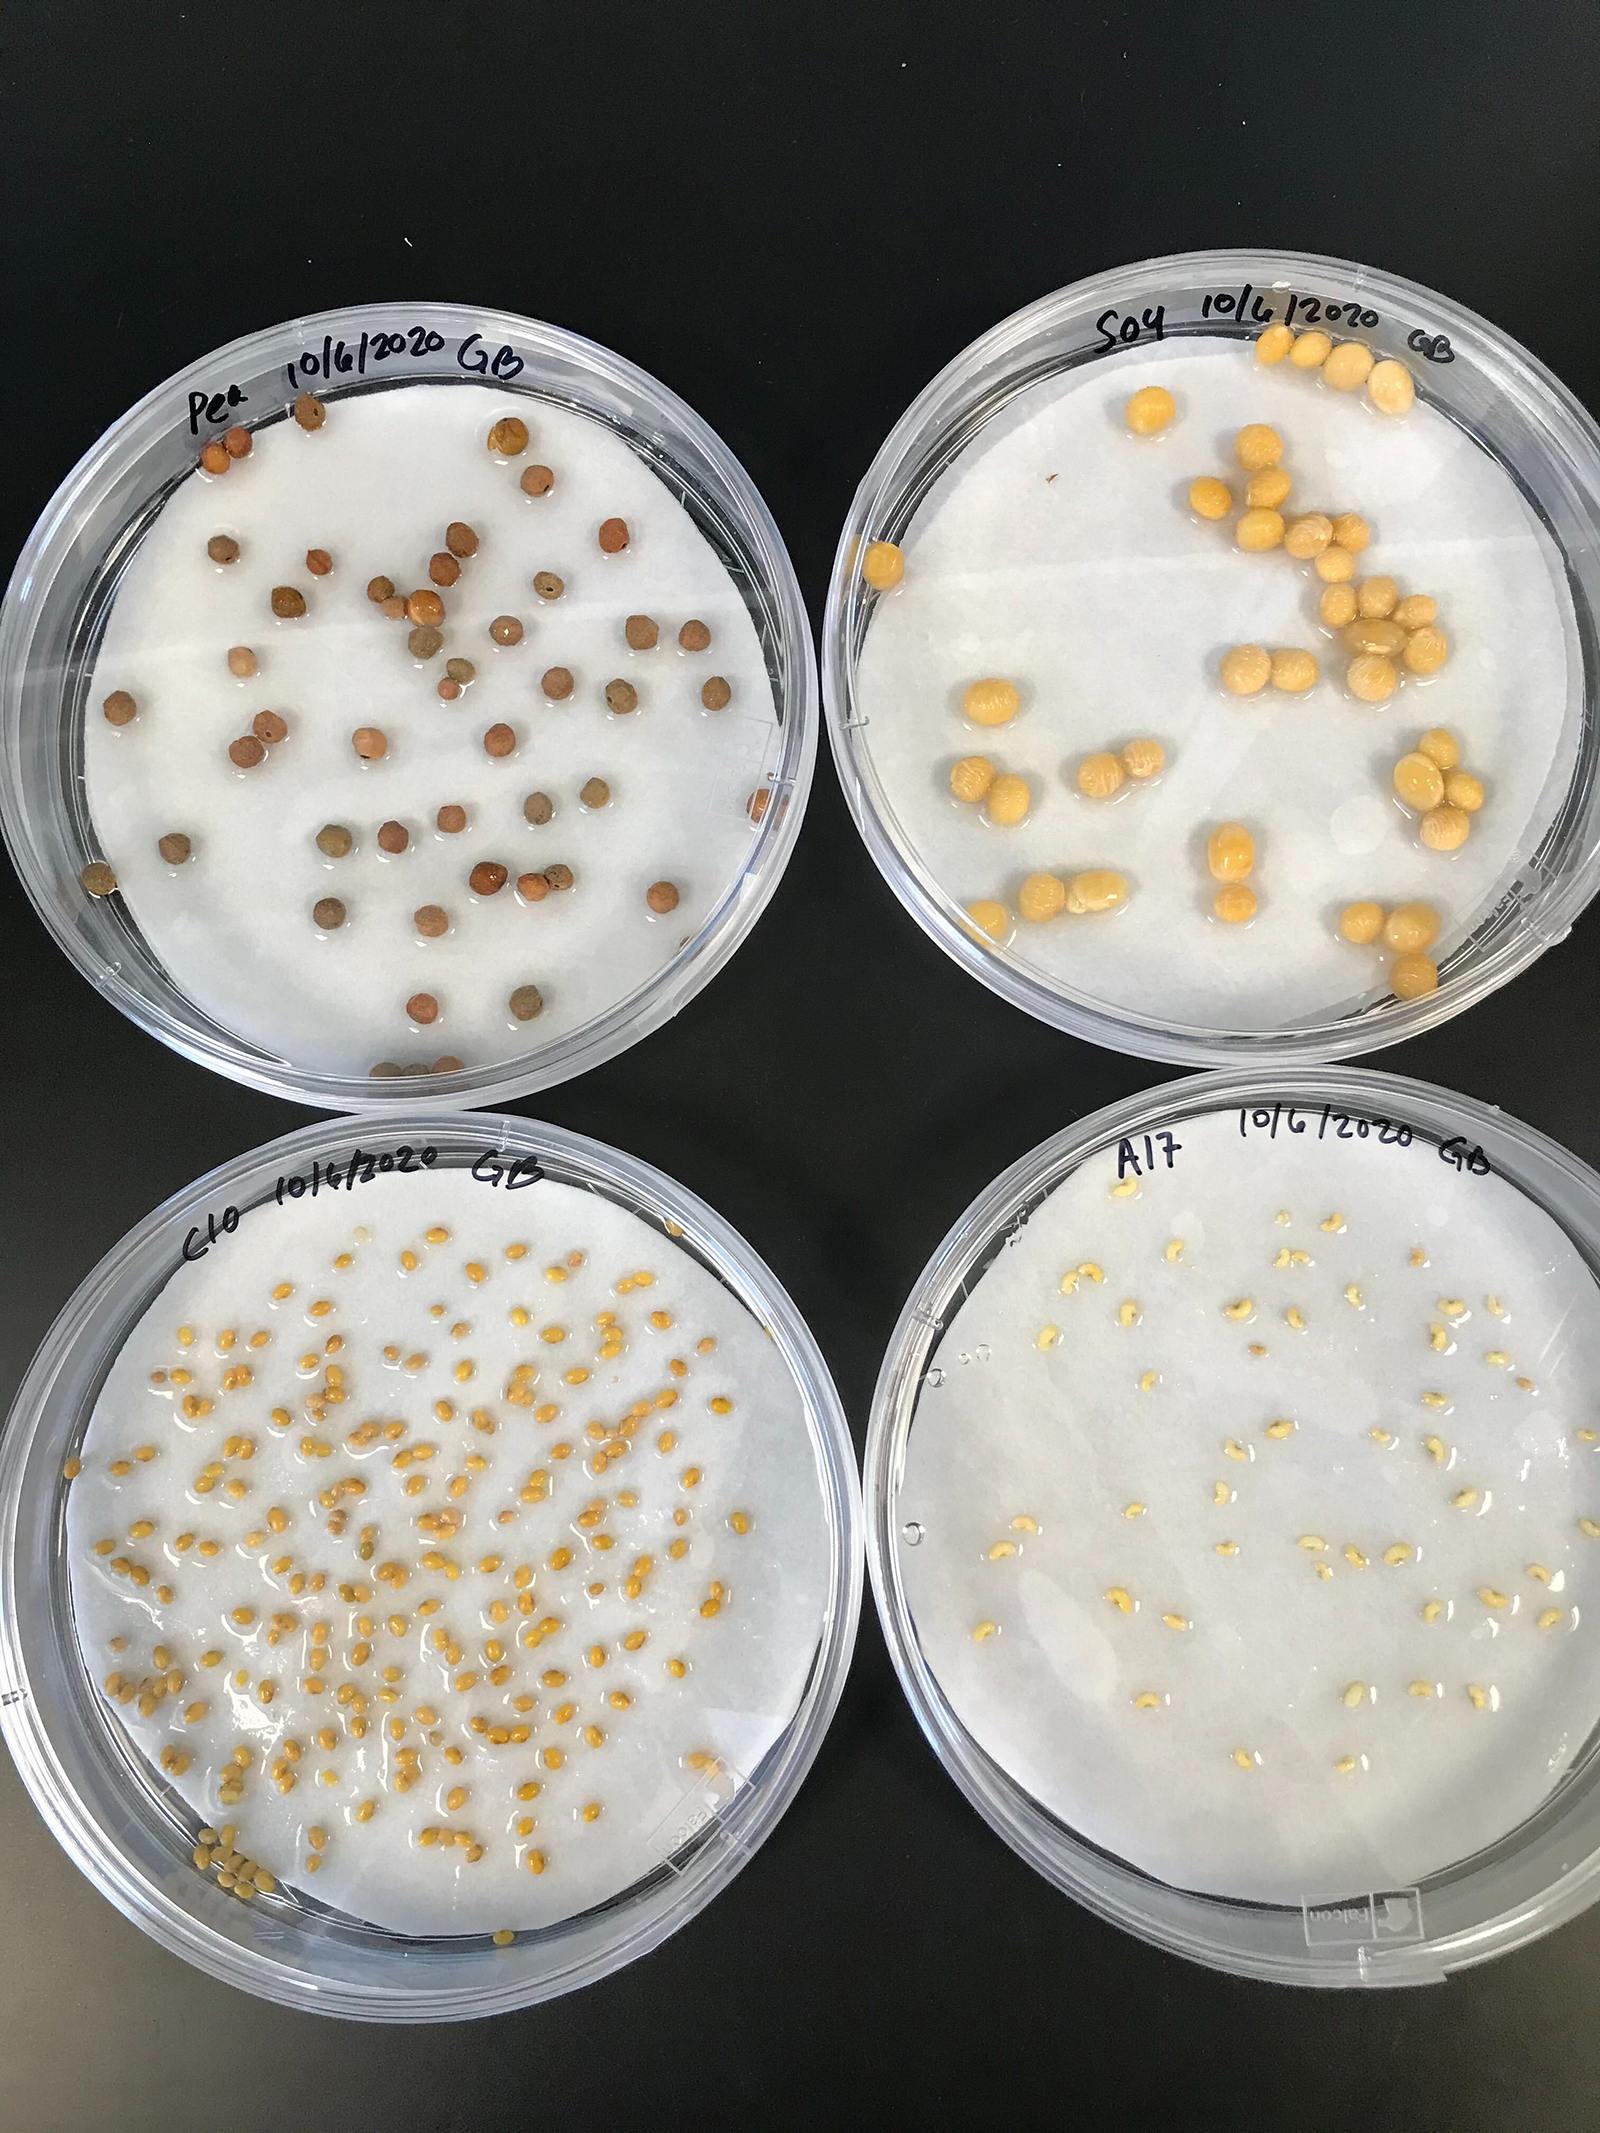

Burghardt Lab Members received fellowships and awards in 2023!
- Jenn Harris received the USDA Predoctoral Fellowship: Click to read more
- Kelsey Mercurio received an NSF Predoctoral Fellowship: Click to read more
- Maria Alejandra Gil-Polo is an Interdisciplinary Innovation Fellow at the One Health Microbiome Center: Click here to read more
Lab members presented at the ASPB Conference in Savannah, Georgia!
- Graduate Student Jenn Harris received a travel award from ASPB to present: Exploring microbial habitat use across the soil, rhizosphere, and root continuum with BONCAT
- Patrick Sydow presented: Variation in Nodule Morphology and Host Selectivityin Legume-Rhizobia Symbiosis Across 202 M. truncatula Accessions
- Former lab undergraduate researcher Liz Paillan presented: Examining Environmental and Genetic Drivers of Alfalfa Nodulation and Nodule Branching Over Time and Space
- Liana Burghardt presented a talk in the Nitrogen Fixation Session: From genes to genera: Assessing genetic determinants of rhizobia fitness in legume nodules across scales


Three lab members presented at the IS-MPMI Conference in Providence, Rhode Island
- Post Doc Sohini Guha received a travel award from MPMI to present: Perturbation of known Medicago symbiosis genes has variable effects on host and rhizobial fitness in multi-strain inoculations
- Graduate Student Maria Alejandra Gil Polo presented a poster entitled: Do rhizobia with divergent morphologies co-isolated from Pennsylvania alfalfa fields alter host growth and strain competition?
- Liana organized a symposium with Sonali Roy highlighting undergraduate research and mentoring and a career networking session and presented a poster.
Six lab members (Liz, Jenn, Lily, Maria, Gina, and Liana) attended or presented at the Changing Microbiomes Symposium at PSU, which brought together ~120 scientists from all over the world (Liana co-chaired the organizing committee and helped garner USDA conference funding for 20 travel awards). The Symposium was hosted by the PSU Huck Microbome Center and will occur again in 2024.


Three lab members (Maria, Gina, and Liana) presented at the North American Nitrogen Fixation Meeting which brought together ~150 scientists from North America. Liana was a member of the scientific organizing committee. The Symposium was hosted by Jean Michel Ane at UW Madison and will occur again in 2024 at the University of Vermont.
The lab has new funding from USDA! See this write-up in PSU today: New plant science team gets grants from USDA-NIFA to research beneficial soil microbes


This spring, lab graduate students Jenn and Maria participated in an 8 part grant writing workshop series and support group led by Terry Bell, Jill Hamilton, and Liana Burghardt and supported by the Huck Institute. This is the third iteration of our grant writing workshop series. Participating Ecology Graduate student Sarah Richards published a nice write-up of the workshop in the Ecology News Letter.
In the Fall of 2021, Liana helped organize a Women in Science Panel Discussion Centered around the award-winning Documentary “Picture a Scientist”
